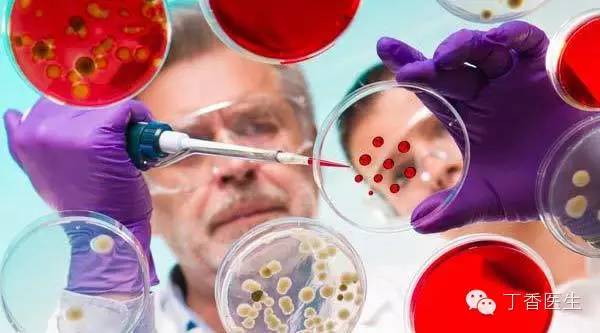

关于疟疾和青蒿素的十个最常见问题
日期:2015/10/17

2015 年 10 月 5 日,2015 年度诺贝尔生理学或医学奖颁发给了我国的屠呦呦(读作:Tu You You)教授。这也是我国研究者第一次获得诺贝尔科技类奖项。
这个奖,正是为了奖励屠呦呦教授和她的团队发现的青蒿素在世界抗击疟疾斗争中做出的伟大贡献。但在祝贺屠教授获奖的时候,想必许多人对疟疾这个疾病和青蒿素这个药物并不熟悉,丁香医生趁此机会就常见问题给大家解释解释。
疟疾是由一种叫作疟原虫的寄生虫引起的传染性疾病。它通过受感染的蚊子叮咬进行传播。这种寄生虫在人体的肝脏中繁殖,然后感染破坏血红细胞,不断繁殖,不断破坏。在所有热带病中,以受疟疾威胁的人数与发病数字为最多,居世界卫生组织重点研究的六大热带病的首位。
感染疟疾,在被蚊子叮咬 10~15 天后,人会出现发烧、头痛和呕吐等症状,民间称作「打摆子」,就是一会儿发热,一会觉得寒冷而打冷战。如果疟原虫侵入脑部血管,则会导致最为严重的脑部疟疾,通常会造成病人昏迷。严重的疟疾患者甚至会因此丢掉生命。
根据 2014 年 12 月发布的情况估计,2013 年约有 1.98 亿疟疾病例,有 58.4 万人死亡。大多数死亡发生在非洲儿童中,那里每分钟便有一名儿童死于疟疾。在我国,经过医学工作者和疾控部门的多年努力,全国疟疾病人由 20 世纪 70 年代初的 2 400 多万减少到目前的数十万,部分省份现只见散发病例,我们甚至有望在 2050 年全面消灭疟疾。
所以,疟疾已经逐渐离我们远去,这其中离不开青蒿素做出的贡献。

青蒿素(读作:Qing Hao Su)是从青蒿等植物中提取出的有效成分,治疗疟疾用得较多的是青蒿素及其衍生物。它作用于原虫膜系结构,损害核膜、线粒体外膜等结构从而杀灭红细胞内的疟原虫起到抗疟作用。
除了青蒿素,目前抗疟药物还包括奎宁类药物(氯喹、伯氨喹)。
氯喹针对疟原虫红细胞内期,可用作控制症状,是非耐药疟疾的首选药物。伯氨喹能杀死肝细胞内期及配子体,是目前唯一可供使用的预防复发和传播的药物。
青蒿素,吸收快,起效快,适用于凶险疟疾的抢救。其中,青蒿琥酯的抗疟作用疗效显著、不良反应轻而少,耐药率很低,已在世界范围内广泛使用,尤其适用于孕妇和脑型疟疾患者。
青蒿琥酯、甲氟喹对治疗耐药疟原虫感染效果好,不良反应轻、价格便宜,在妊娠妇女及儿童中安全,是很多国家对付疟疾的首选用药。
跟抗生素一样,随着一种单一抗疟药物的使用增多,疟原虫便对既往的常规药物(如氯喹)产生了耐药性,此时就需要另外一种药物来治疗。而青蒿素作为较新的药物,对疟原虫的效果明显。
对抗疟疾,我们不需要自己购买药物治疗,更应该重视预防。
疟疾作为一种经蚊虫叮咬传播的传染病,对此不熟悉的读者们,需要做好以下工作:
-
到疟疾肆虐地区之前应该先做好防疫措施;
-
使用蚊香、蚊帐、防蚊喷液等手段来防止蚊虫叮咬;
-
被蚊虫叮咬后,假如出现发烧、寒战交替的症状要及时就医,遵医嘱接受正规治疗。
很遗憾,不是。
在诺贝尔奖颁奖典礼后的发布会上,一位中国记者问道:「这次诺贝尔医学奖算不算是颁发给了中国传统医学?」
诺奖委员会的成员给出了否定的回答,并做出了解释:
非常重要的一点:我们并没有把这个奖项颁发给传统医学,我们是把诺贝尔奖颁给了受到传统医学启发并能从中开发出一种造福全世界的新药的科学家。所以,你可以说是受了中医启发,但不能说是颁给中医。
在这里,「受传统医学启发」是非常严谨、恰当的表达。
首先,青蒿素并不是中药,而是一种在植物中提取出来的单一成分的化学药,有明确的化学结构。就像典型的西药阿司匹林一样,也是从树皮中提取出来的。单单这一点,就和一些人心目中「纯天然、非化学」的中药不同。
其次,青蒿素是通过现代的药理、化学的方法从传统草药中分离出有效成分,用现代医学的方法验证药理药效,整个研究都处在现代医学、药学的科学框架下的。疗效和毒性都非常明确,这和传统的中药也有很大的不同。
不过,青蒿素的发现,确实受到了中国传统医学的启发,在传统药方中,有可能还有一些有效的药用成分因为中国传统医学落后的研究手段而不能为我们所知。和世界上许多国家的传统医学一样,我国中医理论仍存在着其局限性。
在中国历史上,每年都有大量因为疟疾失掉生命的人民,没有哪一个药方能治愈疟疾,这也是因为当时的许多治疗仍然停留在对世界的直觉性猜测和主观的经验总结上,并没有一个科学的方法从中找到单一的有效成分。我们期待,未来会有更多像青蒿素一样的对植物药的现代化改造。
作为首位获得诺贝尔科学奖项的中国人,屠呦呦教授为世界抗击疟疾的事业做出了巨大的贡献,她和她的团队对于中药改造的伟大成就也将载入史册。
信息来源:丁香网
|